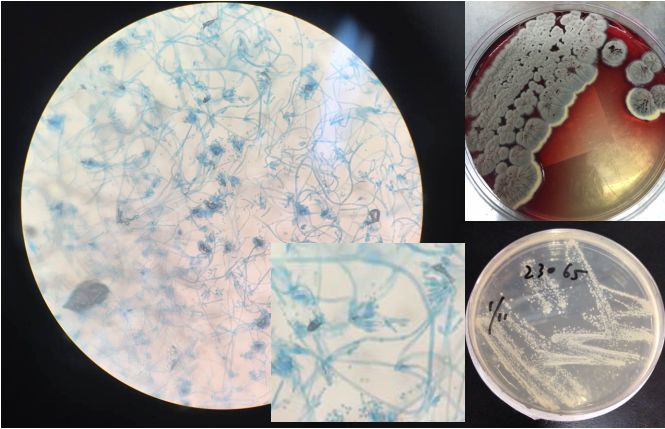
抗核治疗后反而病情加重？这个病例太经典了！

中山呼吸半月谈,今天带来经典病例解析~
来源|医学界呼吸频道
旅游之后,好像有点不对......
老王是温州人,今年64岁了,发病前刚去韩国旅游过,回来后就出现了持续性发热(38℃~38.5℃)伴咳嗽、咳痰、盗汗等症状,同时出现两侧颈部淋巴结肿大伴触痛。2015年11月遂至当地医院就诊,辅助检查结果如下:
■ 查血常规(-);CRP:130.2mg/L;ESR:72mm/H;肿瘤标志物(-);自身抗体(-)。
■ 胸部增强CT示:右肺门、纵膈内隆突下、气管前腔静脉后及胸廓入口处多发淋巴结增大,考虑淋巴瘤可能大,两侧少许胸腔积液,两肺下叶少许渗出,右肺中叶少许纤维灶(图1)。

图12015.12.1当地医院胸部增强CT(抗痨治疗前)
■ 纤支镜检查:未见明显异常,刷检未见抗酸杆菌、肿瘤细胞。E-BUS下纵隔淋巴结穿刺:见大量中性粒细胞、淋巴细胞及坏死物,结核性淋巴结炎可能大。
■ 右锁骨上肿块穿刺病理:慢性化脓性肉芽肿性炎伴淋巴组织增生,结核不除外。
■ 查痰抗酸杆菌(-);T-SPOT:A抗原0,B抗原 2。
结核?抗核治疗结果却是这样......
外院给予诊断性抗结核治疗(利福平0.45g qd+异烟肼0.3g qd+乙胺丁醇0.75g qd+吡嗪酰胺0.75g bid+左氧氟沙星0.5g qd),并加用泼尼松10mg bid抗炎。治疗3周左右患者症状无显著改善。
■ 2015-12-25复查胸部CT:纵隔内及右肺门多发肿大淋巴结,较前有所增大,右肺渗出,右肺中叶部分实变,右侧胸腔积液(图2)。

图2.2015.12.25当地医院胸部CT(抗痨治疗后纵隔淋巴结有增大)
疑云重重:结核?骨髓瘤?
2015年12月29日,老王来到复旦大学附属中山医院呼吸内科入院治疗。叶医生回顾了既往病史并完善了相关检查。
■ 个人既往有糖尿病史10余年,血糖控制不佳。否认高血压、冠心病等慢性疾病史。既往吸烟,量不多,已戒,否认喝酒等不良嗜好。
■ 入院查体 :T 36.8℃,P 102次/分,律齐,R 20次/分,BP:122/73mmHg。呼吸平稳, 口唇无发绀,两侧颈部淋巴结肿大伴触痛明显。双肺可闻及少量湿啰音。心律齐,各瓣膜区未及杂音。腹软无压痛,肝脾未及肿大,双下肢无水肿。
■ 辅助检查:WBC 10.95*109/L;CRP:126.9mg/L;ESR >120mm/H;D-二聚体1.53mg/L;自身抗体 抗核抗体:1:100,余阴性;细胞免疫功能:CD3 48.0%,CD4 22.0%,自然*伤杀**细胞(CD56+16) 33.0%。痰培养 (-);肺炎支原体弱阳性;T-SPOT:A孔0,B孔 0;EB病毒壳抗体IgM (+),巨细胞病毒IgG>500,风疹病毒IgG >500,G试验1-3-β-D葡聚糖 251.4。胸水常规:浑浊,蛋白定性(+),比重 1.034,红细胞 200/mm3,白细胞500/mm3,淋巴细胞95%,中性粒细胞5%;胸水生化:LDH 598 U/L,蛋白 47.16 g/L,葡萄糖 9.8mmol/L;胸水细菌、真菌培养(-)。PET/CT: 右侧锁骨区、胸内及肝胃间隙、肝门区、胰头周围糖代谢异常增高的肿大淋巴结双侧颈血管旁炎性淋巴结可能, 两肺慢性炎症, 双侧胸腔、心包腔积液, 全身骨髓、脾脏弥漫性糖代谢增高(图3,4)。

图3. 2015.12.30 PET-CT显示多发淋巴结肿大伴弥漫性代谢增高

图4. 2015.12.30 PET-CT显示双侧胸腔及心包腔积液
■ 行骨髓穿刺活检术,骨穿结果示造血组织三系细胞均可见到,三系细胞轻度增生,三系细胞形态未见明显异常。免疫组化结果示淋巴细胞数目不增多,浆细胞数目稍增多,约占骨髓有核细胞的10%,增生浆细胞κ、λ均可见到阳性反应,为浆细胞增生性病变,未见到淋巴瘤累及骨髓证据。
病危!到底怎么了?
老王入院后,给予常规抗感染对症治疗,气喘进行性加重,短期内出现双侧大量胸腔积液,大量心包积液伴双下肢浮肿,继发呼吸衰竭、心功能衰竭。复查胸部CT示双侧胸腔积液和心包积液较前明显增多(图5)。

图5. 2016.1.7复查胸部CT提示胸腔积液快速进展
心电图示房颤伴快速心室率。心超示中到大量心包积液,心尖见一实质性等回声团,无法行心包穿刺(图6)。

图6. 心超示中到大量的心包积液,心尖见一实质性等回声团
告病危,予以强心、利尿、扩冠纠正心衰,积极补充白蛋白等处理,症状仍无改善。
一锤定音:原来是TA!
面对这样棘手的情况,金医生认为,解开问题的关键钥匙还在淋巴结中。
再做一次淋巴结穿刺!
老王2016年1月4日在超声引导下再行颈部淋巴结穿刺,穿刺组织内见较多组织细胞及中性粒细胞,组织细胞内见较多PAS染色阳性空泡样物,考虑真菌感染,倾向马尔尼菲青霉菌感染。免疫组化:CK广(-), CD68(组织细胞+)。特殊染色: PAS(+), 六胺银(+), 抗酸(-) 。活检组织培养: 真菌阳性,倾向马尔尼菲青霉菌(图7)。
图7. 淋巴结脓性分泌物培养结果(镜下及肉眼表现)
同时借阅当地医院送检组织,镜下见淋巴组织,其间可见坏死伴中性粒细胞及组织细胞浸润,经特殊染色,组织细胞内可见大量球形空泡样物,考虑真菌感染,倾向马尔尼菲青霉菌。免疫组化: LCA(++), CD20(部分+), CD3(部分+), CD21(-), 特殊染色: PAS(+), 六胺银(+), 抗酸(-)。
2016年1月8日起给予伊曲康唑+甲强龙40mg/日治疗,同时予以对症支持治疗后,患者症状逐渐改善。此后激素逐渐减量至口服,后停用。
2016年1月28日 胸部CT示病变明显吸收(图8)。

图8. 2016.1.28胸部CT示抗真菌+激素治疗20天病灶明显吸收
遂予以出院,回当地医院继续抗真菌治疗。出院后随访至今,患者病情稳定(图9)

图9.2016.5.5当地医院复查胸部CT示双侧胸水及心包积液明显吸收,纵隔淋巴结明显缩小(抗真菌治疗4月)

专家点评

金美玲教授 复旦大学附属中山医院呼吸科
马尔尼菲青霉菌为条件性致病真菌,大多发生在免疫功能缺陷患者。该患者糖尿病,血糖控制不佳,存在免疫功能受损状态。流行病学上,该种疾病大多发生在东南亚国家,国内广东、广西、湖南、浙江温州地区多发,该患者为温州人。临床表现可有发热、畏寒、咳嗽、咳痰、消瘦乏力、肝和脾及浅淋巴结肿大、皮疹、皮下结节或脓肿等。首发症状常为肺部感染、淋巴结肿大,感染可局限性或全身播散,可累及全身各脏器。生化检查中,白细胞计数显著增多,同时可有不同程度的贫血。影像学示肺部浸润性炎症及淋巴结肿大。病理上,以肉芽肿型、化脓性、坏死型三种表现多见。诊断上主要依靠病原学检查。临床上需要鉴别诊断的疾病包括: 结核病(特别需要注意抗结核治疗会加重马尔尼菲的疾病程度)、组织胞浆菌病等。治疗上,主要治疗药物包括两性霉素B、氟胞嘧啶、唑类药物(如咪康唑、酮康唑、伊曲康唑)等。此类疾病预后较好,通过早发现,早诊断,早治疗,药量足,疗程长,马尔尼菲青霉病可以治愈。
在此病例的诊治过程中病理学、病原学诊断非常重要。辅助科室(病理科、细菌室)的全力协助、正确判断,促使该少见病被及时明确诊断。目前真菌感染成为常见病,对于各种不典型表现的,要想到真菌感染的可能性,真菌感染进展迅速,要给予高度重视。
预告预告,今天五点半中山呼吸CPC直播又来啦,精彩继续,不容错过!
